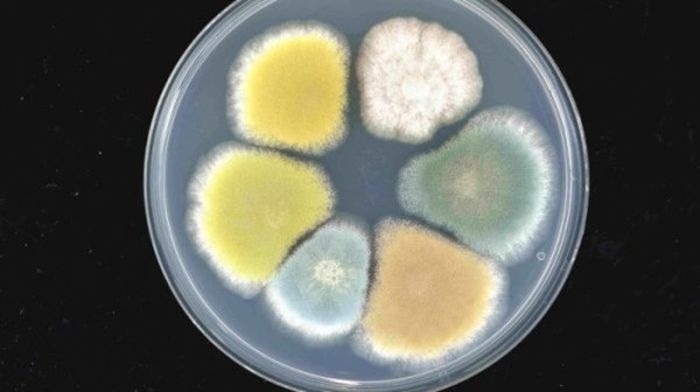

Рокфор, горгонзолу и подобные сыры с плесенью узнают по характерным голубым прожилкам. Исследователи выяснили, как грибы, придающие сырам изысканный вкус, создают этот цвет, не самый типичный для еды.
Необычный цвет, как и вкус — дело плесневого грибка Penicillium roqueforti, который добавляют на ранних этапах сыроварения. Затем во время созревания в сыр вводятся металлические шипы, создающие в сыре небольшие заполненные воздухом ходы, по которым гриб может расти и выделять сине-зеленые споры, придающие сыру голубизну.
Разрастаясь, за пару месяцев созревания сыра плесень производит до 200 летучих соединений, — в частности, метилкетонов, придающих голубым сырам тот самый вкус со множеством оттенков. 
Исследователи выяснили, что за сине-зеленый цвет отвечают целых шесть генов, — и при поломке каждого из них цвет меняется, — на белый, желтый, зеленый, бежевый… А вкус при этом остается прежним.
«Это открывает захватывающие перспективы использования в будущем производстве сыра», — пишут авторы исследования.
На фото – шесть вариантов гриба Penicillium roqueforti, у каждого из которых остановлен один из шести генов, участвующих в выработке сине-зеленого пигмента. Новость-то может и малозначительная, хоть от нее слюнки текут, но интересен сам биотех-подход к приготовлению еды.





